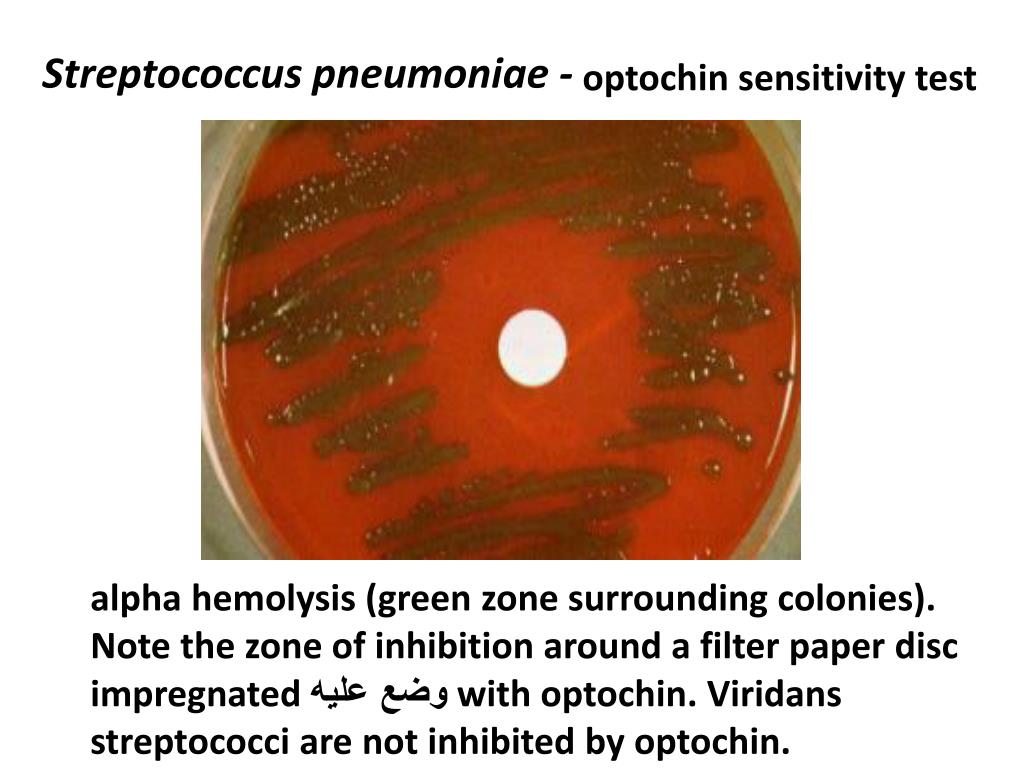
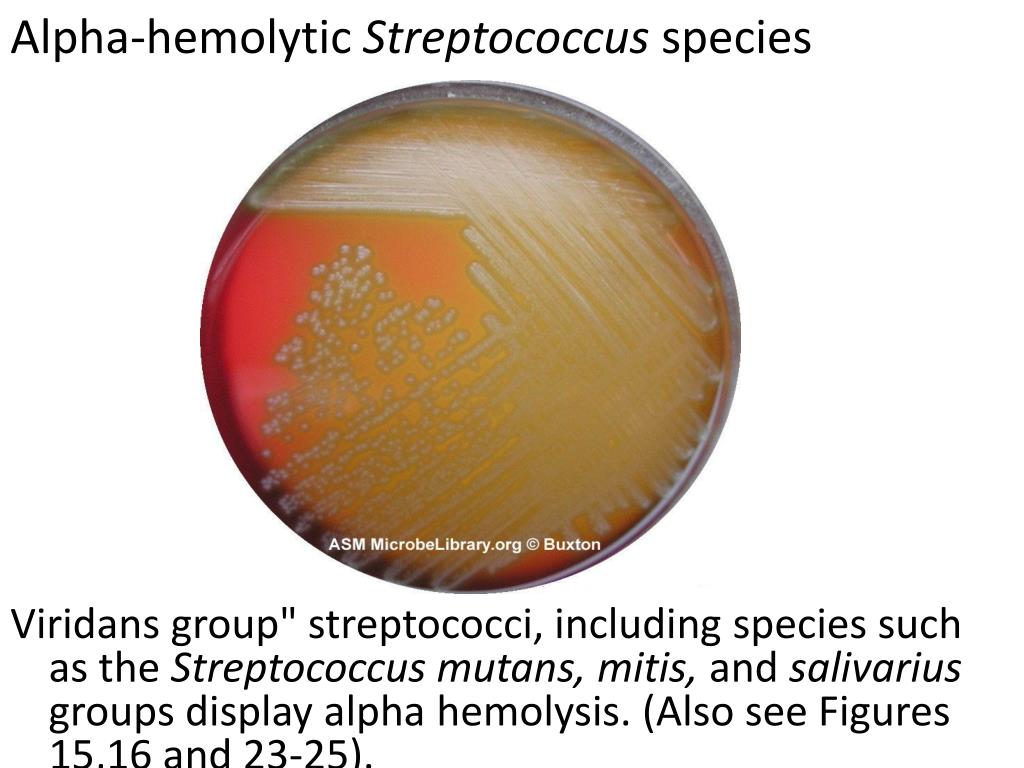

Стрептококк кандида
Стрептококк кандида 105 фото
Bmw e60 дорест
Культура речевого взаимодействия
Цель родительского комитета
Картинки платья рисунки
Признаки причастия состоявшее
Телепрограмма explorer
Антифриз форд куга 2 2.5
Midnight paradise андроид
Овечий навоз для огорода польза и вред
Болезнь костей пальце